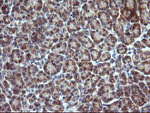
CHGA Antibody in Immunohistochemistry (Paraffin) (IHC (P))
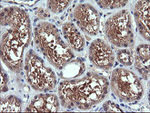
CHGA Antibody in Immunohistochemistry (Paraffin) (IHC (P))

Search
OriGene
CHGA Monoclonal Antibody (OTI1H2), TrueMAB™
{{$productOrderCtrl.translations['antibody.pdp.commerceCard.promotion.promotions']}}
{{$productOrderCtrl.translations['antibody.pdp.commerceCard.promotion.viewpromo']}}
{{$productOrderCtrl.translations['antibody.pdp.commerceCard.promotion.promocode']}}: {{promo.promoCode}} {{promo.promoTitle}} {{promo.promoDescription}}. {{$productOrderCtrl.translations['antibody.pdp.commerceCard.promotion.learnmore']}}
产品信息
TA506120
种属反应
宿主/亚型
分类
类型
克隆号
抗原
偶联物
形式
浓度
规格
纯化类型
保存液
内含物
保存条件
运输条件
靶标信息
Chromogranin A (CHGA) is a member of the chromogranin/secretogranin family of neuroendocrine secretory proteins. It is found in secretory vesicles of neurons and endocine cells. CHGA is a precursor to three biologically active peptides: vasostatin, pancreastatin, and parastatin. These peptides act as autocine or paracrine negative modulators of the neuroendocrine system. CHGA is an excellent marker for carcinoid tumors, pheo-chromocytomas, paragangliomas, and other neuro-endocrine tumors. Coexpression of chromogranin A and neuron specific enolase (NSE) is common in neuroendocrine neoplasms.
仅用于科研。不用于诊断过程。未经明确授权不得转售。
篇参考文献 (0)
生物信息学
蛋白别名: betagranin (N-terminal fragment of chromogranin A); catestatin; CgA; chromofungin; chromogranin A; chromogranin A precursor; Chromogranin-A; CTNNB; DKFZp686D02253; FLJ25606; FLJ37923; MGC105435; parathyroid secretory protein 1; Pituitary secretory protein I; SP-I; unnamed protein product
基因别名: CGA; CHGA; PHE5; PHES
UniProt ID: (Human) P10645
Entrez Gene ID: (Human) 1113